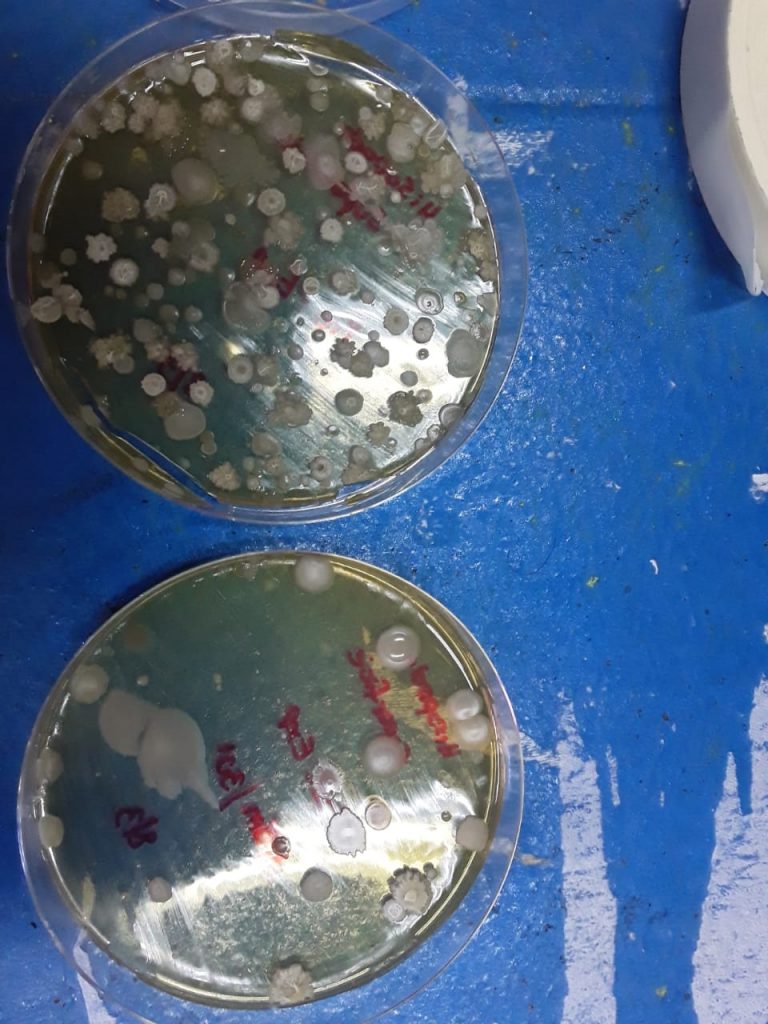

El dispositivo comprobó una eficacia del 99,9% para eliminar tanto bacterias como hongos ambientales a partir de 20 minutos de exposición.

Sin lugar a dudas los recursos destinados a educación y particularmente a la investigación, representan para toda sociedad una inversión a futuro, con ganancias inmanentes que se ven reflejadas en los avances y soluciones a problemas comunes de una nación.
En nuestra provincia, como parte del trabajo final del alumno Claudio Fuster de la carrera de Ingeniería en Electrónica de la UNSE, fabricó un dispositivo electrónico que utiliza rayos UV para sanitizar ambientes y superficies, logrando una alta eficacia del 99,9% para eliminar tanto bacterias como hongos ambientales, que constituyen los principales agentes causales de infecciones comunitarias y hospitalarias, a partir de 20 minutos de exposición.

En TierraDentro diario, charlamos con Claudio Fuster, quien nos comentó: «La iniciativa surgió de una charla con el Ing. Carlos Maguna (asesor del proyecto), nos metimos en ese tema que no es nada nuevo, ya fue utilizado en distintas partes del mundo para sanear ambientes a través de rayos UV, como por ejemplo en los Estados Unidos, en el metro, para sanear tanto ambiente como superficies, mas en el contexto de pandemia que vivimos, provocado por el SARS-cov-2, y que hace imperioso el tratamiento de los ambientes que son comunes para un número importante de personas».
«Es así que el ing. Maguna propone el proyecto ante el rectorado por su aplicación, practica y funcional, en la desinfección de las aulas de la universidad dando un marco de mayor seguridad para brindar clases presenciales, teniendo presente los protocolos vigentes para las instituciones educativas, siendo positiva la respuesta en cuanto a la financiación del proyecto a través de La Facultad de Ciencias Exactas y Tecnologías en su totalidad; primero para fabricar un prototipo y probar y luego cuatro mas, dada la eficacia en las pruebas ahora se esta pensando en uno por aula», nos comentó Fuster al contarnos sobre su proyecto.
Para el proyecto se conformó un equipo interdisciplinario integrado por: la doctora en química Ana Ledesma (docente- investigadora FCEyT/CIBAAL-UNSE-CONICET) y la doctora en Ciencias Biológicas Ana Yanina Bustos (docente-investigadora CIBAAL-UNSE-CONICET/FAyA y FHCSyS), el Téc. Marcos Coronel, el Ing. Carlos Maguna (asesor del proyecto) y Claudio Fuster estudiante de la carrera en ingeniería en electrónica.
Características del dispositivo

El dispositivo de sanitización esta formado por 4 tubos fluorescentes, montados sobre una estructura de caños estructurales e irradia a 360 grados. El sistema esta automatizado, controlable desde una app para el sistema operativo android diseñada para tal fin mediante open source (código abierto). Se vincula la lámpara por bluetooth y se puede programar y ejecutar el tiempo de irradiación para lograr la óptima sanitización.

En este sentido Fuster aclaró: «todo lo generamos con open source (codigo abierto), como así también para programar el aplicativo en Android, para que pueda ser replicado sin gastar demasiado, ya que no fue pensado con fines comerciales, asimismo todo se fabricó en la universidad, todo fue elaborado en nuestra Facultad, incluso una parte está fabricada con la impresora 3D con que cuenta la FCEyT.».
Además esta provista por dos sensores de movimiento, uno fijo y el otro móvil que se orientan según el ambiente en el que se coloca el dispositivo para detectar cualquier movimiento.
Con respecto al funcionamiento, Fuster señaló: «El sistema se enciende de manera remota, pero si alguien ingresa a la sala donde opera el aparato, como tiene sensores de movimiento, se apaga automáticamente y alerta en el celular que se interrumpió la programación, lo que la hace segura. Esta medida se toma para evitar la exposición de personas a la radiación nociva para los seres vivos».
«El prototipo esta terminado y funcional, ya probado exitosamente en las aulas de la UNSE, ya estamos pensando en algunas mejoras para el equipo como vincularlo no solo por bluetooth sino por wi-fi, o también como purificador de aire aislando las lamparas permitiendo la presencia de las personas en el lugar mientras el equipo va purificando el ambiente, o adaptándolo a equipos de aire acondicionado, son muchas las opciones y los usos que se le puede dar».
Pruebas científicas de los resultados
Los rayos UVC, que sirve para matar gérmenes (entre otros seres vivos), también conocido como UV Germicida o denominado generalmente UVGI (Irradiación Ultravioleta Germicida) es usado para inactivar bacterias, esporas de moho, hongos o virus, por ello su utilización en algunas actividades industriales.
Esta radiación es peligrosa, ya que corta la cadena de ADN de virus, hongos, bacterias, y esto evita que se reproduzcan o repliquen. En el caso de los humanos, puede llegar a producir cáncer de piel o enfermedades de ese tipo. El contacto directo con los ojos también puede causar graves daños irreparables a la vista.
Por ello en este proyecto se puso especial énfasis en la seguridad de las personas dotándolo de elementos que cumplan ese objetivo y particularmente riguroso análisis de su efectividad a través de las investigadoras del Cibaal, que hicieron pruebas de los resultados.

Al respecto la Dra. Bustos indicó: «se realizaron pruebas de inactivación de microorganismos patógenos bacterianos que constituyen los principales agentes causales de infecciones comunitarias y hospitalarias. Las pruebas muestran que: “el tratamiento UV provoca la inactivación total de ambas bacterias testeadas al menor tiempo de exposición (20 min), hasta una distancia de 3 metros».
«Para distancias menores a 0,5 metros, la inactivación total se logra con una exposición de sólo 5 minutos”. En relación a la efectividad de la desinfección en superficies agregó: “se comprobó una eficacia del 99,9% para eliminar tanto bacterias como hongos ambientales a partir de 20 minutos de exposición”. Lo que comprueba, a las claras, la efectividad y funcionalidad del dispositivo.
El estudiante Claudio Fuster se encuentra actualmente terminando de escribir su trabajo final de graduación para su posterior defensa.
Indiscutiblemente, la inversión en educación y en estímulos para la investigación crean el contexto de crecimiento necesario para cualquier nación, desde lo práctico y funcional, como así también sentando las bases para promover el crecimiento, el desarrollo y por sobre todo fortalecer el sistema educativo y la capacidad de producir nuevos conocimientos.


